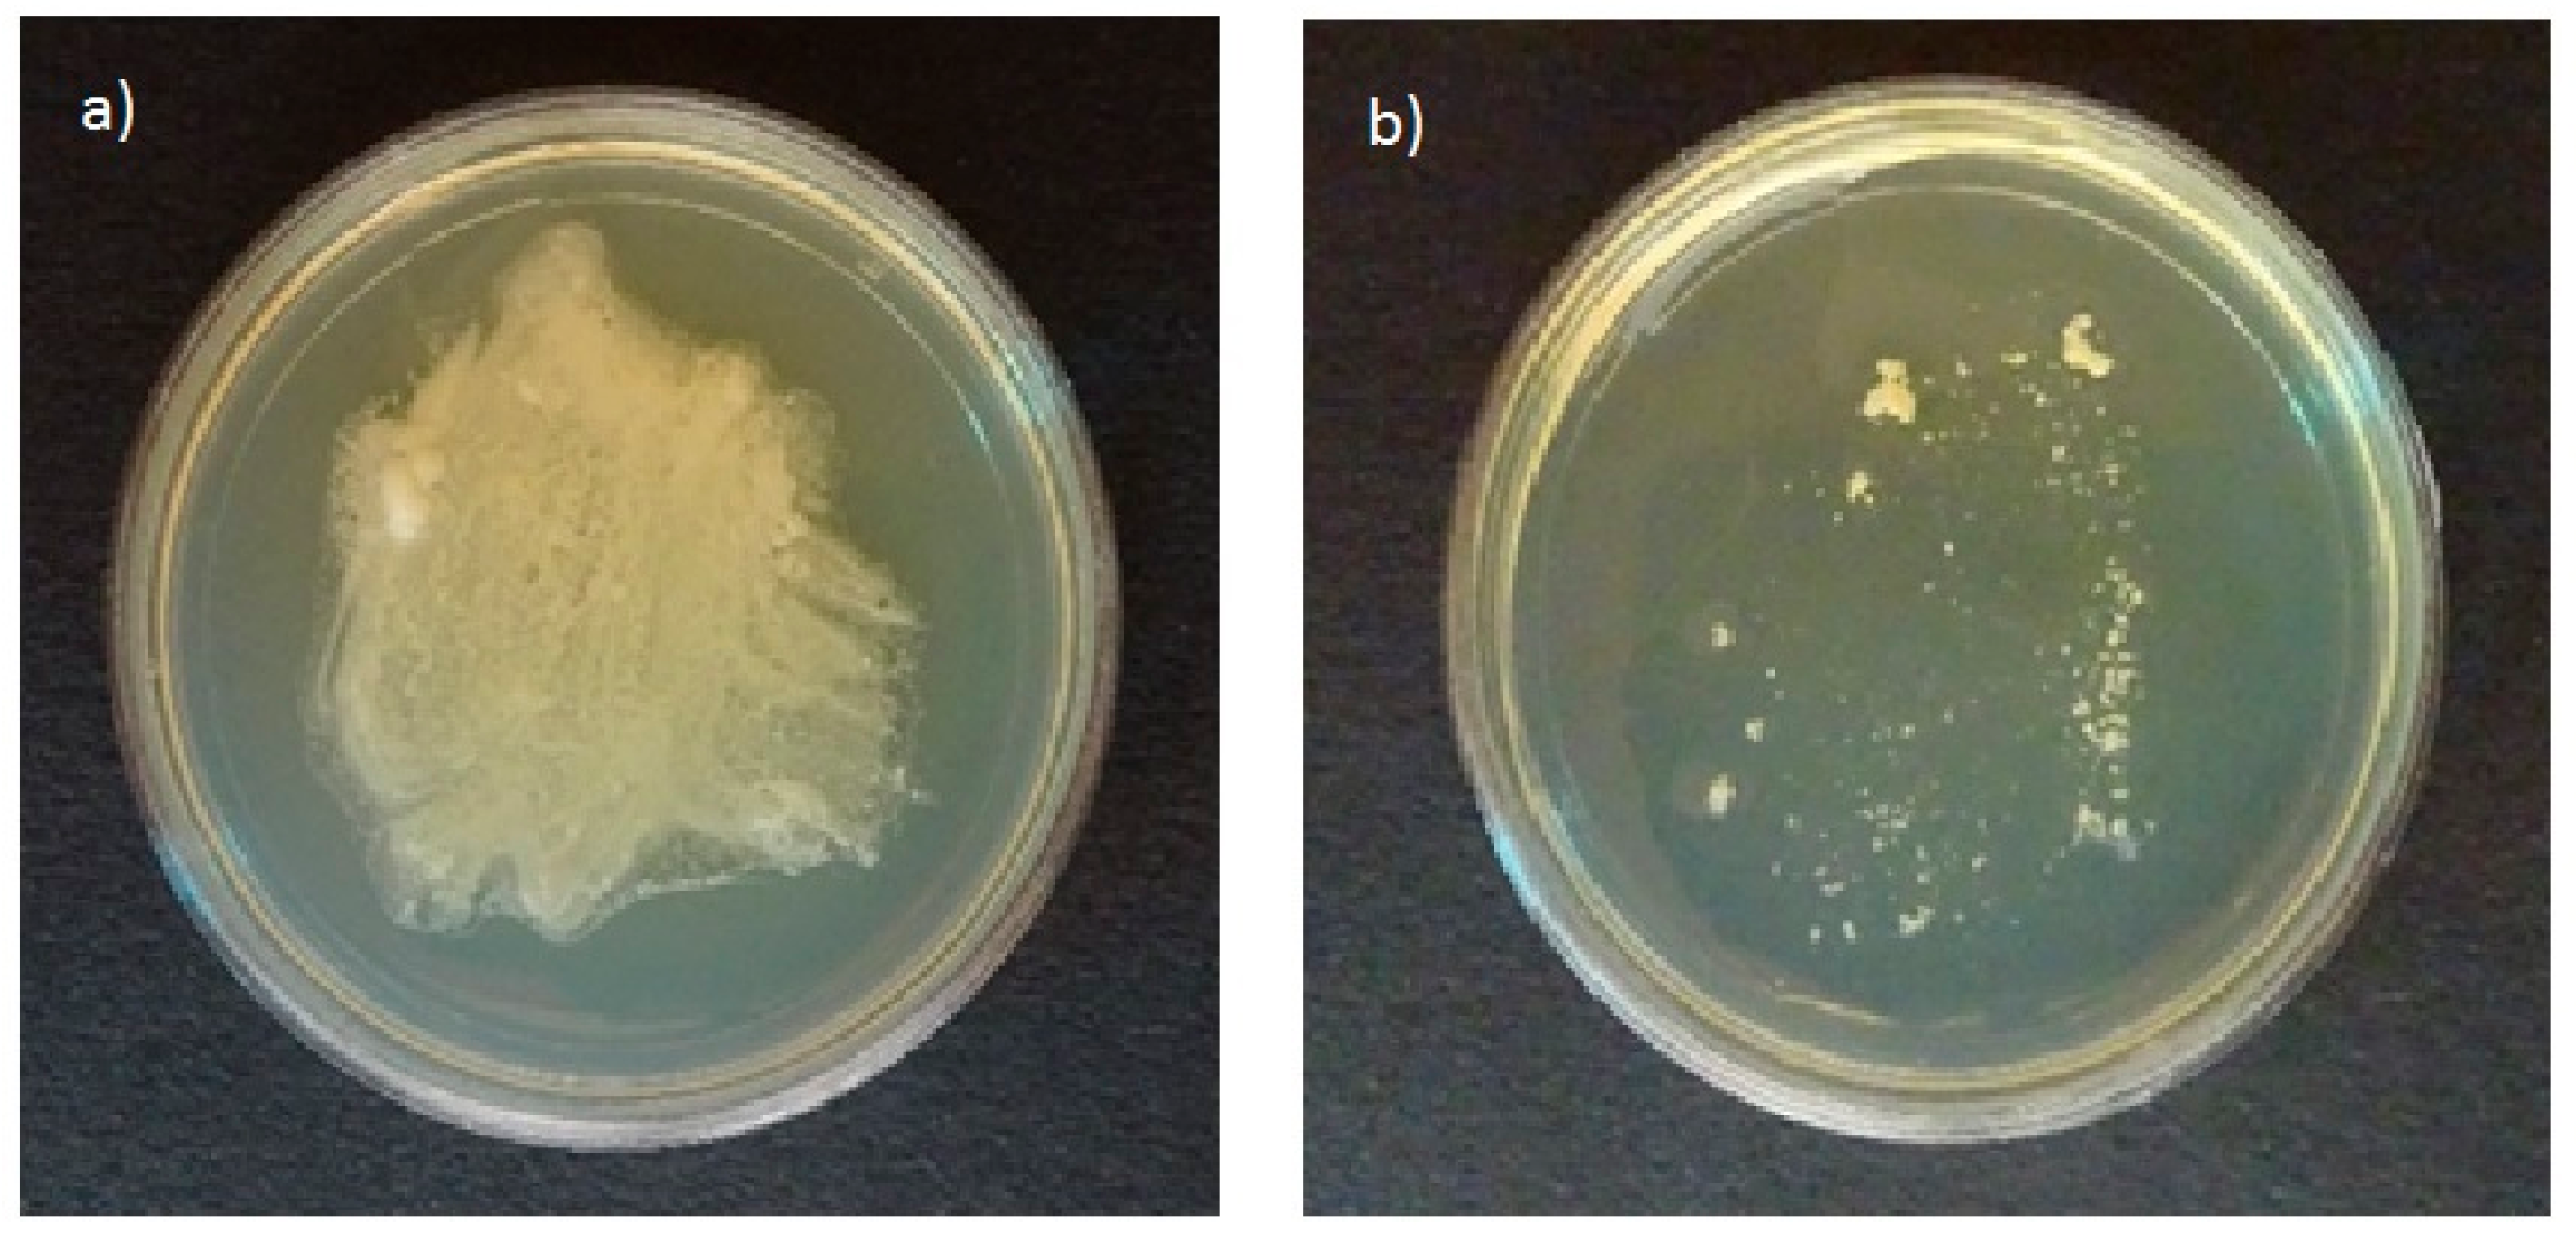
Cosmetics 06 00045 g001

Abstract
Human skin is a complex ecosystem and is host to a large number of microorganisms. When the bacterial ecosystem is balanced and differentiated, skin remains healthy. However, the use of cosmetics can change this balance and promote the appearance of skin diseases. The skin’s microorganisms can utilize some cosmetic components, which either promote their growth, or produce metabolites that influence the skin environment. In this study, we tested the ability of the Malassezia species and some bacterial strains to assimilate substances frequently used in dermal formulations. The growth capability of microorganisms was determined and their lipase activity was analyzed. The growth of all Malassezia spp. in the presence of free acids, free acid esters, and fatty alcohols with a fatty chain length above 12 carbon atoms was observed. No growth was observed in the presence of fatty alcohol ethers, secondary fatty alcohols, paraffin- and silicon-based substances, polymers, polyethylene glycols, quaternary ammonium salts, hydroxy fatty acid esters, or fatty acids and fatty acid esters with a fatty chain length shorter than 12 carbon atoms. The hydrolysis of esters by Malassezia lipases was detected using High Performance Thin Layer Chromatography (HPTLC). The production of free fatty acids as well as fatty alcohols was observed. The growth promotion or inhibition of bacterial strains was only found in the presence of a few ingredients. Based on these results, formulations containing microbiome inert ingredients were developed.
1. Introduction
The skin provides a diversity of habitats for bacteria, yeasts, and mold, with different microbiota associated with different regions of the skin. Based on traditional cultivating methods, the predominant bacteria are Propionibacterium acnes and Staphylococcus spp. in oily sites, and Corynebacterium spp. and Staphylococcus spp. in moist sites. Fungal diversity is dominated by the genus Malassezia [1]. Several of these skin microorganisms are involved in dermatological diseases, such as seborrheic dermatitis, atopic dermatitis, and acne vulgaris [2,3,4].
Malassezia and bacteria such as Staphylococcus spp., Propionibacterium spp., and Corynebacteria spp. secrete multiple lipases with a broad spectrum of activity that hydrolyzes almost all triglycerides in the sebum into fatty acids [5,6,7]. With the exception of M. pachydermatis, all Malassezia species known so far require an external lipid source for growth, i.e., they are inevitably lipid dependent [6]. The Malassezia genome lacks the genes that encode the cytosolic fatty acid synthase complex (FAS), which explains why these yeasts cannot synthesize de novo C14 or C16 free fatty acids (FFAs) [8]. To overcome this, Malassezia utilizes fatty acid sources directly from their host and uses the lipases to obtain FFA. In contrast, most bacteria lack the nutritional advantages offered by the degradation of sebum triglycerides to their constituent free fatty acids. However, the FFAs produced by bacterial lipases promote cell–cell adhesion and the aggregation of cells promotes cooperative cell nutrition due to effects on the local micro-environment [9]. In vitro studies have shown that purified lipases influenced the functions of different human immune cells, such as the chemotaxis of neutrophils and granulocytes, decreasing the phagocytotic killing of bacteria [10]. In this manner, bacterial colonization can be achieved. On the other hand, it has been shown that environmental conditions, including substrates, can influence the fatty acid composition of some bacterial strains [11].
The application of cosmetics may adversely impact skin if microbial numbers and diversity are changed [12]. However, the interactions of cosmetics with microbiota is not yet fully understood. In relation to fungi and bacterial lipases, cosmetic ingredients based on fatty acid esters are of paramount importance. Mayser et al. reported that some emulsifiers and oils promoted the growth of one or more Malassezia species [13]. The same behavior was found by Koyama at al. for other topical vehicles [14]. Growth stimulation and the formation of high amounts of FFAs may be of pathophysiological importance. Additionally, some FFAs produced by the hydrolysis of esters have comedogenic properties and play an important role in the pathogenesis of acne [15]. However, to date no systematic studies have been performed.
In this study, we tested the ability of Malassezia species and different bacteria to assimilate ingredients frequently used in dermal formulations. The growth of microorganisms was determined. Additionally, the metabolism of tested substances was analyzed by High Performance Thin Layer Chromatography (HPTLC).
2. Materials and Methods
2.1. Materials
All tested substances are listed in Table 1. The substances were dissolved or suspended according to their solubility in dimethicone (Evonik, Darmstadt, Germany) or in water, both inert to the growth of relevant microorganisms. The used concentrations were 10% for oils, 5% for emulsifiers, and 2% for fatty acids, gelling agents, and thickeners. Fluid substances were additionally used undiluted.

Table 1.
Tested cosmetic ingredients.
2.2. Formulations
Using the tested substances, water-in-oil emulsions (W/O) and oil-in-water emulsions (O/W) were produced. The emulsions were based on substances showing no interaction with the tested microorganisms. As positive controls, similar formulations containing Olea europaea and Persea gratissima oil (instead of octyldodecanol and caprylic/capric triglyceride) were produced. The composition of both formulations is presented in Table 2.

Table 2.
Composition of the tested emulsions.
2.3. Microorganisms
All microorganisms tested are listed in Table 3.

Table 3.
Strains tested.
2.4. Malassezia spp. Growth Conditions
Cultures were first grown on modified Dixon agar as described by Gueho et al. [16] at 32 °C. After 8 to 10 days, the cells were harvested. One µL of the Malassezia suspension was added together with 100 µL of the substance being tested onto agar selective for pathogenic fungi (Merck, Darmstadt, Germany). Fungal growth was determined at 7 and 14 days.
For determination of metabolic activity, the fungal suspension (approximately 105 CFU/µL) was incubated with the substance being tested for up to 120 h. After the incubation time, the overlay of the petri dish was completely removed with 2 mL of 2-propanol and centrifuged for 5 min at 14,500 rpm. The supernatant was then used for HPTLC analysis.
2.5. Bacterial Growth Conditions
Corynebacterium minutissimum, Staphylococcus epidermidis, and Staphylococcus galinarum were grown at 37 °C on Casein-peptone Soymeal-peptone (CASO) agar. After 24 h, the cells were harvested using a 0.9% NaCl solution. One hundred µL of the bacterial suspension was added together with 100 µL of the substance being tested on the appropriate deficient agar. The composition is shown in Table 4. Bacterial growth was determined after 24 h.

Table 4.
Composition of deficient agar.
2.6. Determination of Malassezia spp. and Bacterial Growth
Malassezia species growth was determined visually at 7 and 14 days.
Bacterial growth was determined by plate counting, and if possible, with the OD600 assay. For plate counting, the samples were diluted in a 0.9% NaCl solution to obtain 30 to 300 colonies on a plate. In the OD600 assay, the absorption of the suspension was measured at 600 nm on a UV 1600PC Spectrometer (VWR, Darmstadt, Germany). Previously, a calibration curve was constructed by correlating OD600 values to bacterial counts.
2.7. HPTLC
To determine the metabolic activity of Malassezia spp., high performance thin layer chromatography was performed based on previously published research [17]. Ten µL of each sample was dissolved in 2-propanol and applied to HPTLC Silica 60 plates (Merck, Darmstadt, Germany) with a Linomat V-applicator (Camag, Muttenz, Switzerland) and separated by HPTLC (mobile phase hexane: diethylether: formic acid 80:20:2 v:v:v). After development, the plate was dipped in a solution of primulin (Sigma-Aldrich, Taufkirchen, Germany) (stock 0.1% in methyl alcohol; final solution in acetone 1:10 v/v). The results were quantified with a Camag TLC Scanner 3 using Camag software (Camag, Muttenz, Switzerland).
3. Results
3.1. Malassezia spp. Growth
All tested strains of Malassezia species grown on plates of agar selective for pathogenic fungi in the presence of olive oil resulted in growth of white colonies on the plates (Figure 1a). In contrast, no growth was found on the agar plates selective for pathogenic fungi without olive oil (Figure 1b). The ability to use olive oil as an external lipid source was reported by Mayser et al. [17]. Thus, agar selective for pathogenic fungi can be used to study the ability of Malassezia species to assimilate cosmetic ingredients.

Figure 1.
Growth profiles of Malassezia furfur on agar plates selective for pathogenic fungi in (a) the presence and (b) the absence of nutritional substances.
The observed growth was strongly dependent on the Malassezia species as well as on the tested substance (Table S1 in Supplementary Materials). The strongest growth was observed for the M. furfur strains. It was also observed that the growth of Malassezia depends on the chemical structure of the tested ingredient. The strongest growth was observed in the presence of natural oils and waxes, primary alcohols, as well in the presence of fatty acid esters with fatty chain lengths above 12 carbon atoms. No growth was observed in the presence of fatty alcohol ethers (e.g., ceteth-20, oleth-20, laureth 20, steareth-20, cetearyl glucoside), secondary fatty alcohols (e.g., octyldodecanol), paraffin- and silicon-based substances, polymers (e.g., hydroxyethyl acrylate/sodium acryloyldimethyl taurate copolymer, cetyl PEG/PPG-10/1 dimethicone, poloxamer 407, acrylates/C10-30 alkyl acrylate crosspolymer), polyethylene glycols, quaternary ammonium salts (e.g., palmitamidopropyltrimonium chloride), hydroxy fatty acid esters, as well as fatty acids and fatty acid esters with fatty chain length shorter than 12C-atoms. However, some exceptions to the above-mentioned rules were observed. In the presence of PEG-40 hydrogenated castor oil and ricinus oil, growth was only observed for the M. furfur strain. In the case of esters containing oleic acid (ethyl oleate, decyl oleate, oleyl oleate, and polyglyceryl-3 oleate) and pure oleic acid, growth was observed for M. furfur and M. sympodialis. No growth was observed for the M. globosa and M. restricta strains.
No growth of all tested Malassezia species was detected in the presence of W/O and O/W emulsions without natural oils. In contrast, a strong growth of all strains was observed in the presence of formulations containing olive and avocado oils.
To determine the metabolic activity of Malassezia spp. an HPTLC analysis was performed. M. furfur 1878, M. globosa 7705, and M. sympodialis 7222 were incubated with isopropyl palmitate, oleic acid, oleyl oleate, or caprylic/capric triglyceride for up to 120 h. In the HPTLC chromatogram, the band corresponding to oleic acid occurs at an Rf of 0.27, the oleyl oleate and isopropyl palmitate bands are observed at and Rf of 0.65, and the caprylic/capric triglyceride band at an Rf of 0.42. After incubation with Malassezia spp., additional bands were detected. The patterns are presented in Table 5. After incubation with oleic acid an additional band at an Rf of 0.56 was observed. The same band was seen for M. furfur when incubated with oleyl oleate. No band corresponding to M. globosa at this Rf was observed. After incubation of oleyl oleate with M. furfur and M. globosa, two additional bands at 0.17 and 0.27 were detected, which correspond to oleic alcohol and oleic acid, respectively. Incubation with isopropyl palmitate resulted in the appearance of an additional band at an Rf of 0.28, corresponding to palmitic acid. After incubation with caprylic/capric triglyceride, an additional band at 0.25 was detected, which corresponds to caprylic and capric acids.

Table 5.
Band patterns observed in High Performance Thin Layer Chromatography (HPTLC) chromatograms after incubation of tested substances with M. furfur 1878, M. globosa 7705, and M. sympodialis 7222.
The hydrolysis rate of isopropyl palmitate and its relationship to cell number for M. sympodialis was investigated. The results, expressed as the isopropyl palmitate to palmitic acid ratio, are shown in Figure 2. It was observed that with a higher number of cells present, a larger portion of isopropyl palmitate was hydrolyzed, suggesting that the hydrolysis rate of isopropyl palmitate was proportional to cell number. An almost linear decrease of isopropyl palmitate was observed over the incubation time. After 72 h, independent of the initial cell number, about 40% of the initial concentration of isopropyl palmitate remained. However, the amount of palmitic acid produced as a result of hydrolysis was lower than expected. A longer incubation time resulted in a relatively lower concentration of palmitic acid. Accordingly, the isopropyl palmitate to palmitic acid ratio was not constant over time.

Figure 2.
The hydrolysis of isopropyl palmitate over time, expressed as the ratio of isopropyl palmitate to palmitic acid (mg/mg) after incubation with M. sympodialis with cell concentrations of 3.6 × 105 cell/µL, 1.8 × 105 cell/µL, and 0.9 × 105 cell/µL.
3.2. Bacterial Growth
A deficient agar for all bacterial species was generated. Agar contains a low amount of nutrients, thus bacterial growth on agar was strongly reduced. The bacteria were incubated with the substances being tested on top of the agar. Peptone was used as a positive control.
No dependence of bacterial growth on general chemical groups of tested substances was found. In most cases, the tested substances had no influence on bacterial growth. However, some exceptions were detected. The most significant interactions were found for C. minutissimum. Thus, capric acid inhibits the growth of all tested strains and oleic acid inhibits the growth of C. minutissimum. The growth of all strains was observed in the presence of sucrose stearate. The growth of C. minutissimum was observed in the presence of ethyl oleate, oleyl oleate, decyl oleate, glycerol oleate, and polyglyceryl-3 oleate. No growth was observed on tested W/O and O/W formulations.
4. Discussion
The human skin is a complex ecosystem with various microenvironmental conditions and hosts many co-existing microorganisms. When the bacterial ecosystem is balanced and varied, the skin remains healthy. However, several environmental factors inclusive of the use of cosmetics can change this balance. Therefore, the influence of cosmetics on microbial diversity and their connection to skin diseases has been explored more extensively in recent years.
Cosmetic products contain many components, which can influence skin microbiome. Some of these, including carbohydrates, proteins, and lipids, can promote microbial growth. On the other hand, they often contain ingredients, e.g., preservatives, which have an inhibitory effect and disturb the microbiota. It has been shown, that cosmetic ingredients influence the skin microbiome and that microbial diversity can significantly change with the use of cosmetics [18,19,20,21,22]. However, to date no systematic studies have been performed.
In the present study, we tested the influence of many different cosmetic ingredients on microorganism growth. We decided to test the substances at concentrations that are used in cosmetic formulations to better simulate their real influence on skin microbiota. The selection of ingredients was based on the most frequently used cosmetic substances according to the Food and Drug Administration (FDA), Deutscher Arzneimittel Codex (DAC) [23], and other previously published studies [24]. A strong influence of certain groups of ingredients on Malassezia spp. growth was found. Natural oils, which mostly consist of fatty acid triglycerides and fatty acid esters with fatty chain lengths above 12C-atoms, presented good growth mediums. It is known that Malassezia cannot synthesize fatty acids, and therefore uses skin sebum as a FFA source. Human sebum is a complex mixture of triglycerides, FFAs, wax esters, sterol esters, cholesterol, cholesterol esters, and squalene [25]. These sources are exploited by Malassezia by secreting lipases and phospholipases to release FFAs from lipids with fatty acid ester bonds [26]. However, there is no strict requirement for them to be glycerol esters [17]. It was shown that besides natural skin components, various other esters can be used by Malassezia as a lipid source. Thus, bacterial growth on natural vegetable oils, emulsifiers, and synthetic oils can also be observed [8,13,14,17]. Our investigations confirm this hypothesis. However, it was apparent that Malassezia metabolism was more complex, and that the chemical structure of an ester can strongly influence its nutritional potential. Mayser at al. showed that the alcohol moiety of the ester strongly influences Malassezia metabolism [17]. The relationship between growth promotion and hydrolysis rate can be arranged in the following order: ethyl ester > isopropyl ester > decyl ester. Additionally, unsaturated fatty acids were more capable of stimulating growth than saturated fatty acids [17]. By testing various esters, we found additional factors that can play a role in growth promotion. One of these factors is the presence of a hydroxyl group on fatty acid backbones. Thus, growth in the presence of PEG-40 hydrogenated castor oil and ricinus oil was observed only for the M. furfur species. In all species, no growth was observed in the presence of macrogol 40 glycerolhydroxystearat. These substances belong to the group of hydroxy fatty acids esters. We tested an additional natural product, lanoline, which is a mixture of hydroxy fatty acid esters (about 30%) with other fatty acid esters (up to 60%) and alcohols. Little or no growth of Malassezia spp. on lanoline was observed. Similar observations were made by Mayser at al. for hydroxy fatty acids, such as PEG glycol-35 castor oil and ricinoleic acid [13]. Growth on this medium was only observed for M. furfur. Therefore, it was assumed that M. furfur is distinct from other Malassezia species with regard to the metabolism of ricinoleic acid. We also demonstrated that these results cannot be extrapolated to other hydroxy fatty acid esters. It is likely that other substances belonging to this chemical group cannot promote the growth of Malassezia. The slow growth of some Malassezia strains on lanoline is probably related to the presence of fatty acid esters other than hydroxy fatty acid esters, which can be metabolized by this species.
Interesting results were obtained using oleic acid as well as esters containing oleic acid. Growth was observed mostly for M. furfur and M. sympodialis species. No growth was observed for M. globosa. However, HPTLC analysis showed an increase in free fatty acids, which could be correlated with the lipase activity of all tested strains. It can be also assumed, that M. globosa cannot used oleic acid as a nutrient. Furthermore, the fungistatic properties of oleic acid against M. globosa and M. restricta strains were reported in a previous study [27]. It is known that M. globosa cannot degrade unsaturated species such as oleic acid due to an absence of the enzyme 2,3-enoyl-CoA isomerase. In the same study, it was shown that M. furfur, in contrast to M. globose, can use oleic acid as a carbon source [27]. However, in another study no growth of M. furfur on oleic acid was observed [28]. The different results may be related to the concentration of the fatty acid used. Mayser used a pure substance, whereas Gordon used concentrations of up to 0.2%. Oleates play an essential role in a number of cellular processes, but at higher concentrations they can have a negative influence on cell survival and cause a lipotoxic effect [29]. In our experiments, apart from hydrolyzed products of fatty acid esters, an additional HPTLC band at an Rf of 0.56 was detected. This band was identified as an ethyl ester [28]. The formation of fatty acid ethyl esters may be an escape mechanism from excess FFAs and was also observed in other strains of yeast [29]. Interestingly, no detectable formation of fatty acid ethyl esters was found during incubation with isopropyl palmitate, indicating a lower toxic potential of palmitic acid compared to oleic acid.
No growth of Malassezia spp. was found on fatty acid esters with fatty chain lengths shorter than 12C-atoms. Medium-chain fatty acids like capric acid (C10:0), caprylic acid (C8:0), or caproic acid (C6:0) are known to have broad antimicrobial activity [30]. The effects of free medium-chain fatty acids on different Malassezia spp. were analyzed by Mayser et al. and all strains tested showed growth reduction after exposure to the free fatty acids [31]. In another study, a similar effect was observed for medium-chain triglycerides [32]. Our experiments confirm these data. No growth was found with capric acid, caprylic/capric triglyceride, cetearyl isononanoate, and polyglyceryl-3 caprate. Using decyl oleate and coco-caprylate/caprate, variable growth was observed. Thus, M. furfur and M. sympodialis showed growth on these media, whereas no growth was observed for M. globosa and M. restricta. These observations are in accordance with the results obtained for oleic acid esters. We can assume that the hydrolysis of esters with a decyl alcohol moiety is faster than the hydrolysis of esters with a coconut alcohol moiety, because of a shorter chain length. Therefore, a higher concentration of oleic acid exists in the medium compared to caprylic/capric acid. M. furfur and M. sympodialis use oleic acid as nutrition, whereas M. globosa cannot use this acid, as explained above. The amount of caprylic/capric acid medium may be too low to have a toxic effect on the species.
Unexpectedly, the growth of some Malassezia spp., especially M. furfur, was observed in the presence of a primary fatty alcohol, cetylstearyl alcohol. No growth was observed with a secondary fatty alcohol, octyldodecanol. Until now, the results of the metabolism of fatty alcohols by Malassezia were not known. Mayser et al. observed no growth of Malassezia spp. on Lanette N and postulated that fatty alcohols cannot be used by this species as nutrition [13]. Lanette N is a mix of ionic surfactant sodium stearyl sulfate and cetylstearyl alcohol. It is possible that the ionic surfactant negatively influences the growth of this species, and therefore no growth was observed. The toxicity of ionic surfactants has been previously reported [33]. Our data suggests that in some cases the metabolism of fatty alcohols by Malassezia may be possible.
No growth of most Malassezia species was observed in the presence of fatty alcohol ether, paraffin- and silicon-based substances, polymers, polyethylene glycols, and quaternary ammonium salts. Thus, the substances based on these chemical groups cannot be assimilated by Malassezia spp. because they either lack fatty acids or the bound fatty acids cannot be cleaved by the Malassezia lipases. However, some exceptions are found for M. furfur. This species is able to grow in the presence of paraffin liquidum and squalene, but its growth is significantly slower than on other growth media. The mechanism of assimilation is not known, but has been previously studied by other research groups [14].
The results obtained with pure substances were evaluated using complex formulations containing several tested ingredients. The results confirm previous observations. Thus, no growth was observed in the presence of formulations containing inert ingredients. In contrast, strong growth was observed for formulations containing natural oils. We assumed that the results obtained for pure substances can be extrapolated to complex formulations.
The utilization rate of cosmetic ingredients on skin is relevant to their potentially harmful effects. Therefore, the hydrolysis rate, its dependence on cell number, and incubation time were estimated for isopropyl palmitate incubated with M. sympodialis. The hydrolysis rate is proportional to cell number, indicating that lipase concentration is cell number dependent. The loss of palmitic acid after a longer incubation time pointed to the assimilation of this substrate by Malassezia. This explains the strong growth of Malassezia on isopropyl palmitate, as well as on other fatty acid esters.
Most of skin’s bacteria are lipid-independent and do not use primarily skin lipids as nutrition. However, some produce lipases, which can hydrolyze skin lipids as well as other fatty acid esters. The hydrolysis of synthetic emulsifiers by staphylococci and corynebacteria has been reported [34]. The lipolytic activity of bacteria is strongly dependent on the strain and on the fatty acid nutrition source [35,36,37,38]. The fatty acids produced by lipases can give some strains of bacteria benefits by occupying skin and by changing the environment pH. Skin bacteria that produce lipases are Staphylococcus spp., Corynebacterium spp., and Propionibacterium spp., among others. We tested the influence of cosmetic ingredients on the growth of resident skin bacteria. In most cases no influence on growth was found; however, some interactions were observed. Capric acid was found to inhibit the growth of all tested strains and oleic acid inhibited the growth of C. minutissimum. The toxic effect of some fatty acids on bacteria is well-documented. Capric acid and lauric acid display a higher bactericidal activity than other saturated fatty acids [39,40]. Fatty acids demonstrate selective bactericidal activity and their influence on bacterial strains is complex [41,42,43]. Nakatsuji et al. found that lauric acid shows a stronger bactericidal activity against S. aureus than that against S. epidermidis [44]. Moreover, Hsuan et al. reported that oleic acid preferentially kills S. aureus and suggested that gram-positive bacteria are more susceptible to fatty acids than are gram-negative bacteria [45]. Furthermore, it was shown that the antimicrobial activity of fatty acids is strongly dependent on pH and concentration. Thus, less concentrated fatty acids, such as oleic acid, can promote growth, whereas high concentrations have antimicrobial effects [43]. We assumed that the concentrations used in our experiments were above the MIC values (minimum inhibitory concentration) for C. minutissimum, causing growth inhibition of this species. In contrast, growth was observed for oleic acid esters: ethyl oleate, oleyl oleate, decyl oleate, glycerol oleate, and polyglyceryl-3 oleate. In this case, oleic acid was bound as an ester and the ester bond must first be cleaved by a lipase to release it. Therefore, the concentration of free oleic acid is considerably lower and can be used by bacteria for growth promotion.
The growth of all bacterial strains observed in the presence of sucrose stearate is attributed to the sucrose moiety, which can be used as an additional carbon source.
In accordance with the results obtained with pure substances, no growth of tested bacterial strains was observed on complex W/O and O/W formulations.
5. Conclusions
Our results show that the use of cosmetic products strongly influences natural skin microbiota. However, this topic is very complex. We tested ingredients that are used in large amounts (above 2%) in formulations in connection with a few microorganisms. On skin, thousands of different species interact together, and therefore a different environment is present compared to that observed in an isolated culture. Therefore, the utilization of cosmetic substances on the skin might be different to the utilization under laboratory conditions. Nevertheless, we could identify groups of substances, which can be problematic in this respect. Specifically, these include free acids, free acid esters, as well fatty alcohols with fatty chain lengths above 12 carbon atoms. In contrast, no interactions were observed in the presence of fatty alcohol ethers, secondary fatty alcohols, paraffin and silicon based substances, polymers, polyethylene glycols, quaternary ammonium salts, hydroxy fatty acid esters, as well fatty acids and fatty acid esters with fatty chain lengths shorter than 12 carbon atoms. The growth influence was observed mostly for Malassezia spp., whereas only a few substances showed an influence on the growth of the tested bacteria. This understanding is especially important for people with dermal diseases such as seborrheic dermatitis or acne vulgaris. Although the pathophysiology of these diseases is not yet completely understood, a correlation with the proliferation of the Malassezia species was verified [3,4]. Based on our data, suitable skin care products for this group of patients can be designed.
Supplementary Materials
The following materials are available online at https://www.mdpi.com/2079-9284/6/3/45/s1, Table S1: Growth of Malassezia spp. on cosmetic ingredients.
Author Contributions
Conceptualization, D.D. and T.S.; methodology, D.D.; validation, D.D. and T.S.; formal analysis, D.D.; investigation, S.W. and I.S.; data curation, D.D.; writing—original draft preparation, D.D.; writing—review and editing, T.S., M.M., and F.R.; visualization, D.D.; supervision, T.S., M.M., and F.R.; project administration, D.D., T.S., and M.M.
Funding
This research was funded by Hessen State Ministry of Higher Education, Research, and Arts, grant number 510/16-22.
Acknowledgments
We acknowledge Peter Mayser and Petra Mayser for technical support and helpful discussions.
Conflicts of Interest
The authors declare no conflict of interest.
References
- Cundell, A.M. Microbial Ecology of the Human Skin. Microb. Ecol. 2018, 76, 113–120. [Google Scholar] [CrossRef] [PubMed]
- Grice, E.A.; Dawson, T.L., Jr. Host-microbe interactions: Malassezia and human skin. Curr. Opin. Microbiol. 2017, 40, 81–87. [Google Scholar] [CrossRef] [PubMed]
- Kim, G.K. Seborrheic Dermatitis and Malassezia species: How Are They Related? J. Clin. Aesthet. Dermatol. 2009, 2, 14–17. [Google Scholar] [PubMed]
- Harada, K.; Saito, M.; Sugita, T.; Tsuboi, R. Malassezia species and their associated skin diseases. J. Dermatol. 2015, 42, 250–257. [Google Scholar] [CrossRef] [PubMed]
- Jaeger, K.E.; Ransac, S.; Dijkstra, B.W.; Colson, C.; Vanheuvel, M.; Misset, O. Bacterial Lipases. FEMS Microbiol. Rev. 1994, 15, 29–63. [Google Scholar] [CrossRef] [PubMed]
- Mayser, P.; Gaitanis, G. Physiology and Biochemistry. In Malassezia and the Skin; Springer: Berlin/Heidelberg, Germany, 2010. [Google Scholar]
- Pablo, G.; Hammons, A.; Bradley, S.; Fulton, J.E. Characteristics of the Extracellular Lipases from Corynebacterium Acnes and Staphylococcus Epidermis. J. Investig. Dermatol. 1974, 63, 231–238. [Google Scholar] [CrossRef] [PubMed]
- Porro, M.N.; Passi, S.; Caprill, F.; Nazzaro, P.; Morpurgo, G. Growth requirements and lipid metabolism of Pityrosporum orbiculare. J. Investig. Dermatol. 1976, 66, 178–182. [Google Scholar] [CrossRef] [PubMed]
- Gribbon, E.M.; Cunliffe, W.J.; Holland, K.T. Interaction of Propionibacterium acnes with skin lipids in vitro. J. Gen. Microbiol. 1993, 139, 1745–1751. [Google Scholar] [CrossRef] [PubMed]
- Rollof, J.; Braconier, J.H.; Soderstrom, C.; Nilsson-Ehle, P. Interference of Staphylococcus aureus lipase with human granulocyte function. Eur. J. Clin. Microbiol. Infect. Dis. 1988, 7, 505–510. [Google Scholar] [CrossRef] [PubMed]
- Chevalier, J.; Pommier, M.T.; Cremieux, A.; Michel, G. Influence of Tween 80 on the mycolic acid composition of three cutaneous corynebacteria. J. Gen. Microbiol. 1988, 134, 2457–2461. [Google Scholar] [CrossRef]
- Holland, K.T.; Bojar, R.A. Cosmetics: What is Their Influence on the Skin Microflora? Am. J. Clin. Dermatol. 2002, 3, 445–449. [Google Scholar] [CrossRef] [PubMed]
- Mayser, P.; Haze, P.; Papavassilis, C.; Pickel, M.; Gruender, K.; Gueho, E. Differentiation of Malassezia species: Selectivity of cremophor EL, castor oil and ricinoleic acid for M. furfur. Br. J. Dermatol. 1997, 137, 208–213. [Google Scholar] [CrossRef] [PubMed]
- Koyama, T.; Kanbe, T.; Kikuchi, A.; Tomita, Y. Effects of topical vehicles on growth of the lipophilic Malassezia species. J. Dermatol. Sci. 2002, 29, 166–170. [Google Scholar] [CrossRef]
- Nordstrom, K.M.; Labows, J.N.; McGinley, K.J.; Leyden, J.J. Characterization of wax esters, triglycerides, and free fatty acids of follicular casts. J. Invest. Dermatol. 1986, 86, 700–705. [Google Scholar] [CrossRef] [PubMed]
- Guého, E.; Midgley, G.; Guillot, J. The genus Malassezia with description of four new species. Antonie Van Leeuwenhoek 1996, 69, 337–355. [Google Scholar] [CrossRef] [PubMed]
- Mayser, P.; Fuhrer, D.; Schmidt, R.; Grunder, K. Hydrolysis of Fatty-Acid Esters by Malassezia-Furfur—Different Utilization Depending on Alcohol Moiety. Acta Derm. Venereol. 1995, 75, 105–109. [Google Scholar] [PubMed]
- Gannesen, A.V.; Borrel, V.; Lefeuvre, L.; Netrusov, A.I.; Plakunov, V.K.; Feuilloley, M.G.J. Effect of two cosmetic compounds on the growth, biofilm formation activity, and surface properties of acneic strains of Cutibacterium acnes and Staphylococcus aureus. Microbiologyopen 2019, 8, e00659. [Google Scholar] [CrossRef] [PubMed]
- Wallen-Russell, C. The Role of Every-Day Cosmetics in Altering the Skin Microbiome: A Study Using Biodiversity. Cosmetics 2018, 6, 2. [Google Scholar] [CrossRef]
- Lee, H.J.; Jeong, S.E.; Lee, S.; Kim, S.; Han, H.; Jeon, C.O. Effects of cosmetics on the skin microbiome of facial cheeks with different hydration levels. Microbiologyopen 2018, 7, e00557. [Google Scholar] [CrossRef]
- Jeong, J.-J.; Kim, D.-H. Effects of Cosmetics and Their Preservatives on the Growth and Composition of Human Skin Microbiota. J. Soc. Cosmet. Sci. Korea 2015, 41, 127–134. [Google Scholar]
- Lalitha, C.; Prasada Rao, P.V.V. Impact of superficial blends on skin micro biota. Int. J. Curr. Pharm. Res. 2013, 5, 61–65. [Google Scholar]
- Govi-Verlag Pharmazeutischer Verlag GmbH. Standardisierte Rezepturen (NRF/SR); Govi-Verlag Pharmazeutischer Verlag GmbH: Eschborn, Germany, 2011. [Google Scholar]
- Belsito, D.V.; Hill, R.A.; Klaassen, C.D.; Liebler, D.C.; Marks, J.G., Jr.; Shank, R.C.; Slaga, T.J.; Snyder, P.W. Plant-Derived Fatty Acid Oils as Used in Cosmetics. Final Rep. 2011, 1–100. Available online: https://purelyprofessional.dk/wp-content/uploads/inci/persea-gratissima-oil.pdf (accessed on 23 July 2019).
- Downing, D.T.; Stewart, M.E.; Wertz, P.W.; Colton, S.W.; Abraham, W.; Strauss, J.S. Skin lipids: An update. J. Investig. Dermatol. 1987, 88, 2s–6s. [Google Scholar] [CrossRef] [PubMed]
- Wilde, P.F.; Stewart, P.S. A study of the fatty acid metabolism of the yeast Pityrosporum ovale. Biochem. J. 1968, 108, 225–231. [Google Scholar] [CrossRef]
- Gordon James, A.; Abraham, K.H.; Cox, D.S.; Moore, A.E.; Pople, J.E. Metabolic analysis of the cutaneous fungi Malassezia globosa and M. restricta for insights on scalp condition and dandruff. Int. J. Cosmet. Sci. 2013, 35, 169–175. [Google Scholar] [CrossRef]
- Mayser, P.; Pickel, M.; Haze, P.; Erdmann, F.; Papavassilis, C.; Schmidt, R. Different utilization of neutral lipids by Malassezia furfur and Malassezia sympodialis. Med. Mycol. 1998, 36, 7–14. [Google Scholar] [CrossRef] [PubMed]
- Connerth, M.; Czabany, T.; Wagner, A.; Zellnig, G.; Leitner, E.; Steyrer, E.; Daum, G. Oleate inhibits steryl ester synthesis and causes liposensitivity in yeast. J. Biol. Chem. 2010, 285, 26832–26841. [Google Scholar] [CrossRef] [PubMed]
- Huang, C.B.; Alimova, Y.; Myers, T.M.; Ebersole, J.L. Short- and medium-chain fatty acids exhibit antimicrobial activity for oral microorganisms. Arch. Oral Biol. 2011, 56, 650–654. [Google Scholar] [CrossRef]
- Mayser, P. Medium chain fatty acid ethyl esters—Activation of antimicrobial effects by Malassezia enzymes. Mycoses 2015, 58, 215–219. [Google Scholar] [CrossRef]
- Papavassilis, C.; Mach, K.K.; Mayser, P.A. Medium-chain triglycerides inhibit growth of Malassezia: Implications for prevention of systemic infection. Crit. Care Med. 1999, 27, 1781–1786. [Google Scholar] [CrossRef]
- Vieira, O.V.; Hartmann, D.O.; Cardoso, C.M.P.; Oberdoerfer, D.; Baptista, M.; Santos, M.A.S.; Almeida, L.; Ramalho-Santos, J.; Vaz, W.L.C. Surfactants as microbicides and contraceptive agents: A systematic in vitro study. PLoS ONE 2008, 3, e2913. [Google Scholar] [CrossRef]
- Kwaszewska, A.; Sobiś-Glinkowska, M.; Szewczyk, E.M. Cohabitation—Relationships of corynebacteria and staphylococci on human skin. Folia Microbiol. 2014, 59, 495–502. [Google Scholar] [CrossRef]
- Sierra, G. A simple method for the detection of lipolytic activity of micro-organisms and some observations on the influence of the contact between cells and fatty substrates. Antonie Van Leeuwenhoek 1957, 23, 15–22. [Google Scholar] [CrossRef]
- Asada, Y. Lipolytic activity of resident flora of the skin: Some observations on lipase activity of Corynebacterium acnes and Staphylococcus epidermis compared with Staphylococcus aureus. Skin Res. 1968, 10, 585–593. [Google Scholar]
- Smith, R.F.; Willett, N.P. Lipolytic Activity of Human Cutaneous Bacteria. Microbiology 1968, 52, 441–445. [Google Scholar] [CrossRef]
- Freinkel, R.K.; Shen, Y. The Origin of Free Fatty Acids in Sebum II: Assay of the Lipases of the Cutaneous Bacteria and Effects of pH*. J. Investig. Dermatol. 1969, 53, 422–427. [Google Scholar] [CrossRef]
- Kabara, J.J.; Swieczkowski, D.M.; Conley, A.J.; Truant, J.P. Fatty acids and derivatives as antimicrobial agents. Antimicrob. Agents Chemother. 1972, 2, 23–28. [Google Scholar] [CrossRef]
- Galbraith, H.; Miller, T.B.; Paton, A.M.; Thompson, J.K. Antibacterial activity of long chain fatty acids and the reversal with calcium, magnesium, ergocalciferol and cholesterol. J. Appl. Bacteriol. 1971, 34, 803–813. [Google Scholar] [CrossRef]
- Smith, R.F. Fatty acid requirements of human cutaneous lipophilic corynebacteria. J. Gen. Microbiol. 1970, 60, 259–263. [Google Scholar] [CrossRef]
- Wille, J.J.; Kydonieus, A. Palmitoleic Acid Isomer (C16:1Δ6) in Human Skin Sebum Is Effective against Gram-Positive Bacteria. Skin Pharmacol. Physiol. 2003, 16, 176–187. [Google Scholar] [CrossRef]
- Ushijima, T.; Takahashi, M.; Ozaki, Y. Acetic, propionic, and oleic acid as the possible factors influencing the predominant residence of some species of Propionibacterium and coagulase-negative Staphylococcus on normal human skin. Can. J. Microbiol. 1984, 30, 647–652. [Google Scholar] [CrossRef]
- Nakatsuji, T.; Kao, M.C.; Fang, J.-Y.; Zouboulis, C.C.; Zhang, L.; Gallo, R.L.; Huang, C.-M. Antimicrobial property of lauric acid against Propionibacterium acnes: Its therapeutic potential for inflammatory acne vulgaris. J. Investig. Dermatol. 2009, 129, 2480–2488. [Google Scholar] [CrossRef]
- Chao-Hsuan, C.; Wang, Y.; Nakatsuji, T.; Liu, Y.T.; Zouboulis, C.; Gallo, R.; Zhang, L.; Hsieh, M.F.; Huang, C.M. An innate bactericidal oleic acid effective against skin infection of methicillin-resistant Staphylococcus aureus: A therapy concordant with evolutionary medicine. J. Microbiol. Biotechnol. 2011, 21, 391–399. [Google Scholar]
© 2019 by the authors. Licensee MDPI, Basel, Switzerland. This article is an open access article distributed under the terms and conditions of the Creative Commons Attribution (CC BY) license (http://creativecommons.org/licenses/by/4.0/).